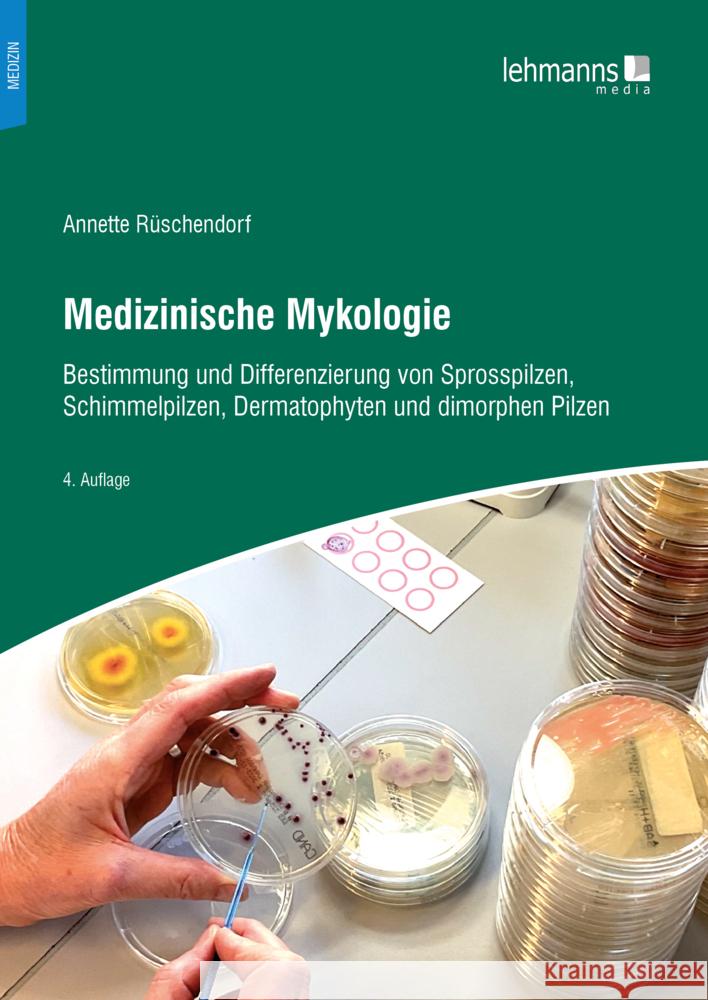
Medizinische Mykologie Rüschendorf, Annette 9783965434455 Lehmanns Media - książka

Medizinische Mykologie » książka
Medizinische Mykologie
ISBN-13: 9783965434455 / Niemiecki / Miękka / 170 str.
Ein Praxisbuch für kleine und mittlere Labore und für die MTA-Ausbildung+Annette Rüschendorf ist Fach-MTA für Mikrobiologie und seit über 30 Jahren in kleinen und mittleren Laboren tätig. Sie hat sich seit etwa 20 Jahren auf humanpathogene Pilze spezialisiert und seitdem sämtliche Hefen, die im Laborbetrieb vorgekommen sind, gesammelt, beobachtet, getestet und fotografiert.Beobachtungen im Laboralltag (u. a. Heferingversuche) zeigten, dass sich viele Laborkräfte "blind" auf die Ergebnisse von industriellen Testkits verlassen, ohne dabei auf ein plausibles Gesamtbild zu achten. Oft passen zum Beispiel das makroskopische Bild einer Pigmentierung oder das mikroskopische Bild eines Reisagars nicht zum Ergebnis, oder es werden einfache Zusatztests zur Absicherung eines Befundes unterlassen. Mangelnde Informationen i. S. eines qualifizierten und preisgünstigen Nachschlagewerkes für den Laboralltag sind hierfür sicherlich ein begünstigender Faktor.Vor diesem Hintergrund ist das vorliegende Buch als übersichtliche und praxisorientierte Einführung in die medizinische Mykologie entstanden. Der Schwerpunkt liegt auf den Sprosspilzen; Schimmelpilze, Dermatophyten und dimorphe Pilze werden insoweit erwähnt, wie es für kleine und mittlere Labore sinnvoll erscheint.Das anwendungsorientiert geschriebene Werk "Medizinische Mykologie" wendet sich an MTA in der Ausbildung sowie im Laborbetrieb und stellt für diese Zielgruppe ein Nachschlagewerk der am häufigsten vorkommenden Pilze sowie ihrer Anzucht und Identifizierung dar; klinische Aspekte werden in Kurzform mitbehandelt.